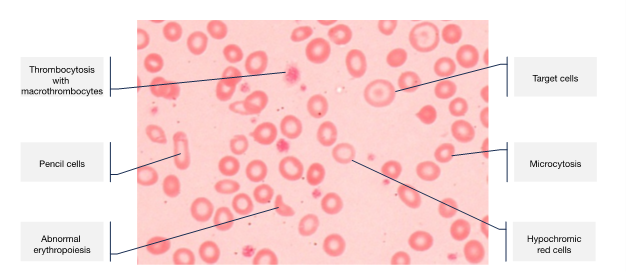
figure 1.png 3

Iron deficiency in women – the silent debilitator
In this article, Dr Sue Pavord explores the effects of low iron on young women and on pregnant women and their fetuses, as well as the wider societal issues it causes.
Introduction
The continued high prevalence and detrimental consequences of iron deficiency (ID) render it a global public health concern. It affects individuals of all ages, sexes and socioeconomic backgrounds. It usually develops slowly over time and can therefore go unrecognised and undiagnosed for many years, with non-specific symptoms attributed to the stresses and strains of normal daily life.
Young women are a particularly high-risk group, owing to regular menstruation and poor dietary intake, with at least a third of women affected worldwide. In pregnancy, ID becomes even more common, due to the increased iron requirements to support development of the placenta and fetus, and expansion of the maternal red cell mass. The recommended daily intake of iron increases from 8 mg/day to 27 mg/day, which is simply unachievable for most women. Iron then needs to be mobilised from body stores. Iron transfer to the fetus is prioritised over maternal needs and maximum transport takes place in the last 5 weeks of gestation.
Impaired erythropoiesis
ID is the most common cause of anaemia. Around 75–80% of total body iron is used by the bone marrow for haemoglobin (Hb) synthesis. The first signs of impaired erythropoiesis are reduction in the size and colour of the red cells (microcytosis and hypochromia), followed by dyserythropoiesis with an increase in red cell distribution width and presence of pencil cells and target cells (Figure 1). An increase in platelet count reflects the stress on the bone marrow.
With progressive iron depletion, erythropoiesis is prioritised to sustain effective tissue oxygenation for as long as possible; iron is first depleted from other body cells. Thus, the effects of ID may be present before anaemia is evident. As iron is essential for the normal functioning of all body cells, these effects can be widespread and debilitating.
Clinical effects of ID and ID anaemia

Symptoms are numerous and broad, and include fatigue, decreased concentration, restless legs, pallor, heart palpitations, dyspnoea, pica (craving for ice, clay, paper or other inedible items), alopecia and dry skin. These symptoms are often overlooked and it isn’t until a routine blood count is taken during pregnancy that anaemia is identified.
Additionally, women with anaemia are at risk of receiving an avoidable blood transfusion, with well-known immediate-, short- and long-term risks. Long-term risks include development of atypical red cell antibodies, which complicates the provision of compatible blood in the future, as well as causing potential for fetal/neonatal haemolytic disease.
Furthermore, ID has wider implications for society (Box 1).
Box 1: The wider societal implications of iron deficiency.
|
Effects of ID in pregnancy
Pregnant women with ID may suffer with fatigue, breathlessness, palpitations, and cognitive and immune dysfunction. In many cases, they may attribute this to the pregnancy itself or caring for young children. Pica and pagophagia (craving for ice) are also common and usually resolve rapidly after iron replacement.
More seriously, iron-depleted women are at increased risk of postpartum haemorrhage, with an inverse relationship between Hb level and estimated blood loss. This is likely due to reduced uterine contractility, but mild coagulation impairment has also been seen in severely iron-deficient women.
Large epidemiological studies have shown a twofold increase in mortality when Hb was below 70 g/L during or after pregnancy (adjusting for confounding factors),1 and for each 10 g/L reduction in Hb, maternal death increased by 29%.2
In the postpartum period, fatigue, depression and impaired mother–child interactions occur and have been shown to improve with iron supplementation.
Effects on the fetus
Despite the preferential delivery of iron to the fetus, ID can lead to the fetus also being compromised. Low cord ferritin levels have been noted when maternal serum ferritin is below 13 µg/L.3 Sufficient iron is vital for fetal brain development, neurotransmitter synthesis and myelin production. Observational studies have found lower Apgar scores and poor cognition in babies born to iron-deficient mothers. Maternal anaemia has also been associated with low birth weight and prematurity.
Managing ID in women
Addressing ID in women requires a comprehensive approach that includes both preventative measures and targeted interventions.
Oral iron supplements
The most common oral iron supplements used in the UK are ferrous sulphate, ferrous gluconate and ferrous fumarate. The optimal dose for absorption is considered to be 40–80 mg elemental iron once daily or on alternate days. Vitamin C may be taken concomitantly to enhance absorption.
Intolerance to oral iron is reduced by correct administration, taking it early in the morning when hepcidin levels are lowest, with a glass of water or freshly squeezed orange juice on an empty stomach, 1 hour before food, drink, multivitamins and medications, which may interfere with absorption. Counselling in correct administration improves tolerance and supports compliance.
Parenteral iron treatment
Intravenous (IV) iron supplementations may be necessary for those with absolute intolerance to oral iron, those who require rapid correction of iron stores or those who are very severely iron-deficient. Preparations include low-molecular iron dextran, iron sucrose, ferumoxytol, ferric gluconate, ferric derisomaltose and ferric carboxymaltose. IV iron supplementation raises the Hb level more quickly than oral iron and avoids gastrointestinal side effects.
Severe adverse reactions to IV iron infusion are rare but some may experience skin staining from extravasation; hypophosphatemia can occur primarily with ferric carboxymaltose, owing to an increase in FGF23 concentration causing phosphaturia. Some IV iron options are offered in small doses, while some preparations allow larger doses for complete iron repletion in just 1 or 2 sessions.
Overall, IV iron supplementation is very safe but should be avoided in the first trimester of pregnancy, owing to the theoretical risk of toxicity to trophoblastic membranes from oxygen-free radicals released during bidirectional change of valence between Fe2+ to Fe3+.
Management in pregnancy
Comprehensive national guidelines for the management of ID in pregnancy have been in place in the UK since 2012 and updated in 2020.4 Data suggests that, where these guidelines are adhered to, maternal anaemia is promptly identified and appropriately managed, and that pre-delivery Hb is improved.
Key recommendations include a routine check of Hb at booking and at 28 weeks’ gestation. If anaemia is diagnosed, a trial of oral iron should be initiated promptly and used as a diagnostic tool, with assessment for Hb response 2–4 weeks later. Counselling in the correct administration is crucial to aid absorption and minimise side effects.
Consideration of those who are not yet anaemic but are at risk of ID is also important. Examples include women with previous anaemia, an interpregnancy interval of less than a year, multiple pregnancy or multiparity. These women should be offered oral iron empirically or, if preferred, have their serum ferritin checked to confirm iron depletion.
A serum ferritin level is needed in women with known haemoglobinopathy to identify concomitant ID and exclude iron-loading states. If haemoglobinopathy status is not yet known, oral iron can be started while awaiting results to avoid delay in treating ID; in the unlikely event of previously undiscovered iron overload, 2 weeks of oral iron will have no material consequence.
IV iron may be indicated, from the second trimester onwards, if there is absolute intolerance or unresponsiveness to oral iron, profound iron depletion (ferritin <10 μg/L) regardless of Hb, or >34 weeks’ gestation with confirmed ID anaemia and Hb <100 g/L where there is insufficient remaining time before delivery for correction of anaemia with oral iron.
Management in the postpartum period
Women at risk of postpartum anaemia because of blood loss >500 ml, uncorrected antenatal anaemia <105 g/L, or symptoms consistent with anaemia should have their Hb checked within 48 hours of delivery. If anaemia is confirmed, IV iron replacement should be implemented. If Hb is under 70 g/L and there is cardiovascular compromise or risk of rebleeding, blood transfusion may be needed. This requires discussion and consent.
It is not known when women can restart oral iron supplements after delivery. Hepcidin levels will be elevated and, until return to baseline, absorption of oral iron will be impaired. Ideally, women should receive oral supplements for a further 3 months to ensure fully replenished iron stores.
Preventative measures
Dietary supplementation with iron-rich food sources is inadequate for treatment of established ID, but it is an important measure in the prevention of ID (Box 2). Advice should be tailored to the individual’s dietary preferences, accommodating cultural and ethical beliefs.
Box 2: Dietary measures for preventing iron deficiency.
|
Heavy menstrual bleeding
Heavy menstrual bleeding (HMB) is underdiagnosed and estimated to affect 18–38% of women of reproductive age. Common causes include uterine fibroids and adenomyosis, as well as underlying bleeding disorders that may be due to the use of anticoagulants or inherited conditions, such as Von Willebrand disease, coagulation factor deficiencies and platelet function disorders. Studies have reported that up to 17% of women attending menorrhagia clinics have an inherited bleeding disorder.5 Other causes of HMB include malignancy, polycystic ovarian syndrome and trauma to the cervix and vagina.
Management strategies for HMB include use of tranexamic acid, combined hormonal contraceptives, progestin-only depo shots, oral gonadotropin-releasing hormone antagonists and hormonal intrauterine devices. More severe or persistent bleeding may require uterine artery embolisation, endometrial ablation, myomectomy or, as a last resort if family planning is complete, a hysterectomy.
Non-anaemic iron depletion is also common in this group, and underdiagnosed. A study of 150 young women who presented with HMB revealed that 50.9% of them had serum ferritin levels of <20 ng/mL, while only 41.4% of these were anaemic.6 Therefore screening for ID in these patients is paramount to enable early oral or IV iron supplementation to prevent anaemia, problems in pregnancy and avoidable or inappropriate blood transfusion.
Around 23% of women preparing for hysterectomy to address HMB are reported to have anaemia; improving Hb levels prior to surgery may improve surgical outcomes and reduce blood transfusion requirements.
Public health measures
Public healthcare strategies to help prevent ID should be considered (Box 3).
Box 3: Public health measures that would help prevent iron deficiency.
|
Conclusion
ID and ID anaemia are significant health concerns with far-reaching consequences on individuals’ health and wellbeing. ID is very common in young women but remains an underdiagnosed, silent debilitator. Understanding the causes, symptoms and prevention strategies related to ID is crucial in promoting women's health, avoiding complications in pregnancy and preventing inappropriate blood transfusion.
The overall burden of ID on society can be reduced by implementing preventative measures, such as nutritional education, improved awareness and availability of iron supplements and fortification of staple foods. It is essential for governments, healthcare professionals and communities to work together to address ID as a public health priority.
References are available on the website.

Dr Sue Pavord
